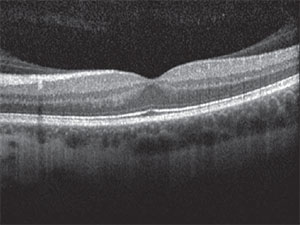

During screening for LASIK, an operculated retinal hole OS in the superotemporal periphery was incidentally discovered. The hole was immediately treated with barrier laser retinopexy. Several months later, she underwent uneventful LASIK surgery and was advised to have yearly dilated retinal exams. She also received education about the warning signs for retinal detachment. At this time, she denied any vision changes, scotomata, flashes, floaters, visual field defects or any other ocular symptoms.
 |
| Figure 1. Widefield fundus photography of the left eye shows a superotemporal operculated retinal hole surrounded by prior laser retinopexy scars, with a shallow cuff of subretinal fluid (arrows) extending beyond the laser scars. |
Examination
Uncorrected visual acuity was 20/20 in both eyes, with intraocular pressures of 10 mmHg bilaterally. No afferent pupillary defect was present. Confrontational visual fields were full in both eyes. Slit lamp examination showed well-healed LASIK flaps in both eyes, and was otherwise unremarkable.
Dilated fundus examination was unremarkable in the right eye and significant for a superotemporal mid-peripheral operculated retinal hole in the left surrounded by a ring of pigmented scars, with shallow subretinal fluid (SRF) extending beyond the laser scars to the edge of the macula.
Diagnosis, Workup, Treatment
Given her exam findings, we informed the patient of her diagnosis of superior macula-sparing rhegmatogenous retinal detachment (RRD) OS. Upon further detailed questioning, we confirmed that she was entirely asymptomatic. We discussed various treatment options with her, including further barrier laser, pneumatic retinopexy with either cryotherapy or laser, primary scleral buckle, vitrectomy or close observation.
Ultimately, the patient was offered immediate supplemental laser retinopexy, with the hopes that laser uptake in the area of shallow SRF would result in an adherent chorioretinal scar. During the procedure, there was some uptake at the temporal margin of the SRF; however, uptake was poor in the area of SRF most threatening to the macula (Figure 1). We asked the patient to limit her activity and follow up in one week, sooner in case of any suspicious symptoms.
|
| Figure 2. Optical coherence tomography of the left eye showed vitreomacular adhesion. |
At one-week follow-up, she was still asymptomatic, and the SRF was roughly stable. Some of the fresh laser marks superotemporally were beginning to show pigmentation, but there was still significant SRF threatening the macula.
The risks, benefits, and alternatives to various treatment strategies were again discussed with the patient. We also asked her to seek a second opinion with another respected retina expert, which she did. Given her young age, occupation requiring stereopsis, phakic status, history of refractive surgery and vitreomacular adhesion as seen on optical coherence tomography (Figure 2), we offered her primary scleral buckle.
Some advantages of this approach for this patient included maintenance of good visual acuity postoperatively, avoidance of the need for postoperative positioning and decreased risk of cataract progression.
During surgery, we identified and marked the retinal break, applied cryotherapy and placed a 240 encircling band with a 276 segmental tire to ensure support of the break, which was relatively posterior in location, approximately 7-8 mm behind the rectus muscle insertions. Given that the SRF was quite shallow, we did not undertake external drainage.
On postoperative day one, the retinal break was well supported and fresh cryotherapy marks could be seen surrounding it. Shallow SRF remained (Figure 3A, page 18). At postoperative month two, the SRF had entirely resolved, and the cryotherapy scars had matured to become pigmented (Figure 3B). At this visit, the patient achieved 20/20 visual acuity with a -2.25 D spherical refraction. The patient’s refractive outcome left her with functional monovision, and she was able to adapt well to a contact lens OS.
Discussion
In the management of a retinal detachment, various options are at the physician’s disposal. However, the treatment of asymptomatic macula-sparing rhegmatogenous detachments remains highly controversial.
Ranging from intraocular surgery to observation, decisions are often made on a case-by-case basis, as no single treatment has been unequivocally demonstrated to be superior to the others. Here we review the five primary options.
Observation. Advocates of observation propose that the risks of therapy may outweigh the presumable benefit of preventing future symptomatic problems. Among other reasons, proponents note that possible consequences of retinal detachment surgery include cataract formation, glaucoma, bleeding, infection, choroidal effusion, cystoid macular edema, macular pucker, diplopia, refractive shift and proliferative vitreoretinopathy.1
In a single-observer, prospective observational case series of 18 eyes, Steven Cohen, MD, found that the natural history of asymptomatic retinal detachments over an average of 46 months of follow-up was to remain asymptomatic and stable for four years, with only one incidence of slight progression that subsequently stabilized.2 He thus concluded that asymptomatic, clinically diagnosed rhegmatogenous retinal detachments can be safely observed on the order of years.
Similarly, Norman Byer, MD, reported two cases of subclinical retinal detachments spontaneously regressing and resolving, with no recurrence in 12-14 years.3 His prospective, natural history cohort study of 19 eyes with asymptomatic retinal breaks likewise found a less than 1 percent per year incidence of progression to clinical retinal detachment.4 A study of 31 eyes with asymptomatic retinal detachments only found two eyes that progressed into symptomatic detachments at two and three years following initial detection,5 and the authors similarly concluded that observation and patient education were reasonable management strategies for this group of patients.
 |
| Figure 3. Widefield fundus photography of the left eye (A) first day postoperatively shows shallow subretinal fluid (SRF), scleral buckle indentation and fresh cryotherapy marks. At two months postoperatively (B), fundus photography shows resolution of SRF and pigmented cryo scars. |
In contrast, Matthew Davis, MD, who defined subclinical retinal detachments as flat detachments extending more than 1 disc diameter from a retinal break, but no more than 2 DD posterior to the equator, has supported the argument for prophylactic intervention. In his analysis of 20 eyes with asymptomatic subclinical detachments followed for six months or more, six of the eyes progressed to clinical retinal detachment.6,7 Similarly, W.H. Jarrett, MD, found progression of retinal detachments in seven of 15 eyes with asymptomatic macula-on retinal detachments during follow-up of up to 10 months.8
Laser retinopexy. In a study of asymptomatic macula-sparing retinal detachments, demarcation laser photocoagulation of shallow RRD without associated proliferative vitreoretinopathy (PVR) was found to be a reasonable alternative to surgical repair, even in eyes with well-established risk factors for progression, including horseshoe tears, vitreous hemorrhage or RRD in the fellow eye.9 As an in-office procedure without the risks of intraocular surgery, demarcation laser photocoagulation is often employed as a primary treatment of asymptomatic retinal detachments.
However, patients must be warned of the potential need for further intervention if the laser barricade is insufficient for blockage of subretinal fluid progression, especially since it takes up to two weeks for the chorioretinal adhesions to fully form.
Laser has theoretical advantages over cryotherapy by inducing less inflammation, discomfort and retinal pigment epithelium dispersion, thereby decreasing risk for epiretinal membrane and PVR formation. Our patient initially underwent laser, but we ultimately felt it was insufficient to reduce the risk of progression.
Pneumatic retinopexy. As a non-incisional treatment option for retinal detachment repair, pneumatic retinopexy was initially advocated for breaks located within 1 o’clock position from the superior two-thirds of the retina.
Additionally, phakic patients were found to have better outcomes with pneumatic retinopexy.10 Since then, the indications for pneumatic retinopexy have grown to include multiple breaks in multiple quadrants.6,11 This procedure is minimally invasive, may be conducted in the office setting, has reduced recovery time and has excellent postoperative visual acuity results.12
However, several studies have demonstrated a statistically lower rate of reattachment with pneumatic retinopexy in comparison to primary scleral buckling.10,13 Additionally, failures after pneumatic retinopexy feature the more prominent risk of PVR that can be visually devastating.14 Younger patients may have a higher risk of PVR formation.15
Patient selection is imperative to the success of the procedure, with ocular, physical and social considerations arguably playing a larger role in the decision-making process than in other procedures. The surgeon must choose whether to employ pre-gas injection cryotherapy or post-gas injection laser as a method of retinopexy, further complicating decision-making.
Scleral buckle. Scleral buckling (SB) has long been considered the gold standard for uncomplicated RRD repair, with longstanding stability of up to 95 percent reattachment at 20 years.16 Benefits of primary SB include long-term support of the vitreous base and less risk of endophthalmitis, cataract progression and other complications of intraocular surgery. Additionally, many SB cases do not require tamponade agents, thus avoiding the need for postoperative positioning and travel restrictions.
However, identification of all retinal breaks and adequate visualization is crucial for surgical success, and a combination of explants, chorioretinal adhesion techniques and drainage of sub-retinal fluid must be employed tactically.
Moreover, induced myopia is inevitable with an encircling band, with various studies citing average spherical equivalent changes of -1 D to -2.75 D.17,18 In our patient’s case, SB enabled faster visual and activity recovery while maintaining good long-term visual outcome.
The most commonly reported causes of primary SB failure include PVR and choroidal detachments, although the Pseudophakic and Aphakic Retinal Detachment Study Group demonstrated a similar frequency of choroidal detachments after SB and PPV.19
In a retrospective review of 28 eyes with asymptomatic clinical retinal detachments that underwent scleral buckling, all patients had excellent anatomic and visual results.20 However, this study lacked a control group for comparison.
Pars plana vitrectomy. With a 71 to 92 percent primary success rate, and a 92 to 95 percent final success rate, PPV is an excellent treatment option for RRDs.21,22 With good visualization of all tears and breaks, as well as the removal of opacities and vitreous traction, this procedure allows for excellent anatomic success in complicated detachments.12
However, in young patients like ours without a pre-existing PVD, PPV is often more challenging. Risks of this intraocular surgery include iatrogenic retinal breaks, PVR, lens trauma and cataract progression,17,23 as well as prolonged postoperative positioning requirements. One might argue that these factors may make vitrectomy the suboptimal choice in an otherwise asymptomatic young patient.
The Decision for Our Patient
Ultimately, the specific clinical situation at hand dictates the management of asymptomatic retinal detachments. This can only be informed from a thorough discussion of risks, benefits and expectations for each possible strategy with affected patients.
 |
The decision to treat our patient was prompted by the high-risk location of her detachment superotemporal to the fovea and her need for stereopsis to continue practicing as a surgeon. The decision for scleral buckle was based upon the patient’s young age, phakic status and need for rapid visual rehabilitation. As in this case, the decision-making process must involve a multifaceted approach and employ the art, as well as the science, of medicine. RS
REFERENCES
1. Williams GA, Aaberg TM Sr. Techniques of scleral buckling. In: Ryan S], editor. Retina, 2nd ed. St. Louis, MO: Mosby;1994:2006-2014.
2. Cohen SM. Natural history of asymptomatic clinical retinal detachments. Am J Ophthalmol. 2005;139:777–779.
3. Byer NE. Spontaneous regression and disappearance of subclinical rhegmatogenous retinal detachment. Am J Ophthalmol. 2001;131:269-270.
4. Schmidt JC, Rodrigues EB, Hoerle S, et al. Primary vitrectomy in complicated rhegmatogenous retinal detachment—a survey of 205 eyes. Ophthalmologica. 2003;217:387-392.
5. Brod RD, Flynn HW, Lightman DA. Asymptomatic rhegmatogenous retinal detachments. Arch Ophthalmol. 1995;113:1030–1032.
6. McAllister IL, Zegarra H, Meyers SM, Gutman FA. Treatment of retinal detachments with multiple breaks by pneumatic retinopexy. Arch Ophthalmol. 1987;105:913–916.
7. Davis MD. The natural history of retinal breaks without detachment. Arch Ophthalmol. 1974;92:183–194.
8. Jarrett WH. Retinal detachment: is reparative surgery always mandatory? Trans Am Ophthmol Soc. 1988;86:307–320.
9. Vrabec TR, Baumal CR. Demarcation laser photocoagulation of selected macula-sparing rhegmatogenous retinal detachments. Ophthalmology. 2000;107:1063-1067.
10. Han DP, Mohsin NC, Guse CE, Hartz A, Tarkanian CN. Comparison of pneumatic retinopexy and scleral buckling in the management of primary rhegmatogenous retinal detachment. Southern Wisconsin Pneumatic Retinopexy Study Group. Am J Ophthalmol. 1998;126:658-668.
11. Tornambe PE, Hilton GF, Kelly NF, Salzano TC, Wells JW, Wendel RT. Expanded indications for pneumatic retinopexy. Ophthalmology 1988;95:597–600.
12. Sodhi A, Leung LS, Do DV, Gower EW, Schein OD, Handa JT. Recent trends in the management of rhegmatogenous retinal detachment. Surv Ophthalmol. 2008;53:50-67.
13. McAllister IL, Meyers SM, Zegarra H, Gutman FA, Zakov ZN, Beck GJ. Comparison of pneumatic retinopexy with alternative surgical techniques. Ophthalmology. 1988;95:877–883.
14. Kovacević D1, Bedenicki I. Complications of pneumatic retinopexy. Coll Antropol. 2001;25 Suppl:97-9.
15. Stopa M, Kociecki J, Rakowicz P, Gotz-Wieckowska A, Rogulska M. Comparison of anatomic and functional results after retinotomy for retinal detachment in pediatric and adult patients. Eur J Ophthalmol. 2013;23:410-416.
16. Schwartz SG, Kuhl DP, McPherson AR, et al: Twenty-year follow-up for scleral buckling. Arch Ophthalmol. 2002;120:325-329.
17. Cheng L, Azen SP, El-Bradey MH, et al: Duration of vitrectomy and postoperative cataract in the vitrectomy for macular hole study. Am J Ophthalmol. 2001;132:881-877.
18. Smiddy WE, Loupe DN, Michelsl RG, Enger C, Glaser BM, deBustros S. Refractive changes after scleral buckling surgery. Arch Ophthalmol. 1989;107:1469-1471.
19. Ahmadieh H, Moradian S, Faghihi H, et al, for the Pseudophakic and Aphakic Retinal Detachment Study Group. Anatomic and visual outcomes of scleral buckling versus primary vitrectomy in pseudophakic and aphakic retinal detachment: six-month follow-up results of a single operation—report no. 1. Ophthalmology. 2005;112:1421-1429.
20. Greven CM, Wall AB, and Slusher MM. Anatomic and visual results in asymptomatic clinical rhegmatogenous retinal detachment repaired by scleral buckling. Am J Ophthalmol. 199;128-618-620.
21. Byer NE. Subclinical retinal detachment resulting from asymptomatic retinal breaks. Ophthalmology 2001;108:1499-1504.
22. Gartry DS, Chignell AH, Franks WA, et al. Pars plana vitrectomy for the treatment of rhegmatogenous retinal detachment uncomplicated by advanced proliferative vitreoretinopathy. Br J Ophthalmol. 1993;77:199-203.
23. Afrashi F, Erakgun T, Akkin C, et al: Conventional buckling surgery or primary vitrectomy with silicone oil tamponade in rhegmatogenous retinal detachment with multiple breaks. Graefes Arch Clin Exp Ophthalmol. 2004; 242:295-300.



